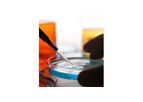
Legionella Testing & Legionella Treatment Services

- Home
- Companies
Refine by
Industries served
- Environmental
- Waste and Recycling
- Water and Wastewater
- Energy
- Soil and Groundwater
- Monitoring and Testing
- Health and Safety
- Construction & Construction Materials
- Oil, Gas & Refineries
- Agriculture
- Air and Climate
- Manufacturing, Other
- Medical / Health Care
- Chemical & Pharmaceuticals
- Mining
- Government
- Metal
- Aerospace & Air Transport
- Food and Beverage
- Automobile & Ground Transport
- Banking & Finance / Insurance / Legal
- Plastics & Resins
- University / Academia / Research
- Electronics and Computers
- Defense
- Pulp & Paper
- Commercial
- Communications / Telecom / Datacom
- Real Estate
- Forestry & Wood
- Maritime/Shipbuild/Water Transport
- Paint
- Textile
- Publishing / Media / Marketing
- Printing
- Packaging
- Logistics
- Glassware
- Dry Cleaning
- Retail
- Travel & Leisure
- Household Appliances
- Leather & Tanning
- Domestic
- Furniture
Environmental Industry Service Provider
3,819 companies found

Service providerbased inBruehl, GERMANY
HIMA is the world’s leading specialist for safety-related automation solutions. HIMA solutions provide maximum safety and maximum availability and can be integrated into any automation environment. More than 35,000 HIMA systems have been installed ...
Thanks to its computing power, a large variety of sensor interfaces and granular architecture, the new HIMatrix M45 is suitable for complex safety-critical applications in the area of logistics and machine safety. It makes safe motion control ...

Service providerbased inLacombe, ALBERTA (CANADA)
Decoking Descaling Technology Inc (DDT) was founded in 1991 by Orlande Sivacoe, the inventor of off-line hydraulic pigging of fired heaters for Delayed Cokers in Oil Refineries and Bitumen Upgraders. Orlande has led the growth of the company to a ...
Service providerbased inPetit-Couronne, FRANCE
As a leading player in the rehabilitation of contaminated sites in Europe, VALGO provides novel turn key solutions that contribute to preserve the environment. Through its technical skills (Deconstruction, Depollution) and engineering skills ...
After an environmental audit of sites/building, we develop and apply deconstruction solutions in which we aim to recover the maximum amount of ...

Service providerbased inNorth Kansas City, MISSOURI (USA)
One Salute specializes in the proper disposal of medical waste, which includes red bag or soft medical waste and sharps disposal. We focus on making our medical waste management services flexible, compliant, and convenient, so you can focus on your ...
One Salute is a perfect partner to a large clientele base in the collection, transportation, treatment and disposal of medical and bio hazardous wastes. We provide comprehensive environmental, industrial and emergency response services to all areas ...
Service providerbased inKilkea, IRELAND
Enviraud is an environmental company that specialise in Environmental & Occupational Monitoring, Environmental Noise & Occupational Noise Monitoring Competency courses, Vibration monitoring, Baseline Audiometric Hearing testing (on-site) and EIA ...

Service providerbased inChattanooga, TENNESSEE (USA)
ACME Industrial Piping is specific to the craft of piping. We provide facility service projects including: welding, rigging and hoisting, maintenance modifications, installation of a variety of piping systems as well as civil, structural and ...
ACME Industrial Piping specializes in manufacturing construction as a 'One Stop' solution in manufacturing construction. These specialties include the installation of machinery, equipment, pumps, as well as structural construction, rigging, and ...

Service providerbased inRockaway, NEW JERSEY (USA)
Rockaway Recycling has been a family run scrap yard since 1977. We have been recycling scrap copper, brass, insulated wire, and steel while serving thousands of customers and keeping millions of pounds of material out of landfills. We will help ...

Service providerbased inSwan Hills, ALBERTA (CANADA)
SENA is an industry leader and global provider of engineering, construction, environmental, infrastructure development, and facility operation services to meet the varied needs of government and industrial clients in our changing world. Our ...

Service providerbased inReston, VIRGINIA (USA)
Constellis was formed in 2010 by a group of operators and investors who sought to combine best-in-class brands, assets and people within the complex risk management industry. Promoting a culture of compliance and operational excellence, the ...
Leaders in Comprehensive Fire Protection and Emergency Medical Support. Constellis has more than 50 years of experience providing fire protection and Emergency Management Services (EMS) services. We deliver comprehensive fire protection and medical ...

Service providerbased inMerseyside, UNITED KINGDOM
Brodex Water Treatment carry out a variety of risk assessment, disinfection & monitoring services of water systems from underground reservoirs and pipework to process systems and entire commercial building services of any ...
One requirement of HTM01-05 is that all dental practices have a valid legionella testing program. An expert external assessment is essential for all legionella treatment that might need to be ...

Service providerbased inNew York, NEW YORK (USA)
Sims Metal Management Limited is the global leader in metals and electronics recycling. Our leadership position has been built through an uncompromising commitment to safety, customer service and the expertise and loyalty of our extraordinary ...
Ferrous and non-ferrous metals come in a myriad of commodities and grades and our experienced consultants are the authority on the intricacies of scrap metal recycling. They build long-term relationships by thoroughly understanding your scrap ...

Service providerbased inNorcross, GEORGIA (US) (USA)
GeoSierra is a privately held corporation, involved in technological innovation in the earth sciences focused on providing more sustainable solutions for issues relating to the Earth, Energy and Environment. GeoSierra is based in Atlanta, GA, USA ...
Frac Enhanced Soil Vapor Extraction: GeoSierra has pioneered the use of inclusion propagation using non-invasive fluids to enhance the permeability of low permeable soils for effective Soil Vapor Extraction (SVE). Tight soils are not amenable to ...

Service providerbased inBrodhead, WISCONSIN (USA)
The Earth Partners LP is a land management and bioenergy company developing next-generation projects to restore marginal and degraded lands. Our unique “land and fiber” approach finds hidden value and risk mitigation opportunities in feedstock ...
Service providerbased inRedvers, SASKATCHEWAN (CANADA)
Epic can provide expert professional supervision of gas plant, oil and gas wells and battery site abandonments. These services include: wellhead gas migration testing and reporting, site assessments, soil and groundwater evaluation, preparation of ...
Epic provides on-site drilling, fluid and cuttings sampling and analysis. Epic technicians are equipped and trained for accurate sampling and analysis as per government requirements. The addition of hydrocarbon test kits provides companies with ...

Service providerbased inCuddy, PENNSYLVANIA (USA)
Nicholson Construction Company has been setting the industry standard for performance and technical innovation in geotechnical construction. As the North American subsidiary of Soletanche Bachy, Nicholson is part of a global network of unparalleled ...
Cutter soil mixing (CSM) provides a cost-effective solution for the rapid construction of retaining and cut-off walls by mixing soil in-situ with a cement/bentonite grout. Like traditional walls, the CSM wall consists of adjacent male and female ...

Service providerbased inMannheim, GERMANY
The company was founded in 1979. G.V.S. received its name – GVS Gesellschaft für die Verbrennung auf See mbH & Co.KG – in 1984. We have been operating in the field of special waste disposal for over 25 years and are proud to number a multitude of ...
As an independent company we are able to recommend the best solution in each case for our customers, without having to consider group obligations to use prescribed places of disposal or abide by compulsory utilization rates. Our employees’ ...
Service providerbased inGeorgetown, CAYMAN ISLANDS
We collect and process and ship non ferrous metals off island for recycling. WE PAY OUR CUSTOMERS FOR THE METALS. We run our small business on our own we owe no moneys and are quite ...

Service providerbased inKnowsley, UNITED KINGDOM
The company was founded in 1988 under the name of Western Speciality Chemicals and traded as a partnership for a number of years.Initially the company was based in Runcorn, Cheshire but due to rapid growth it became necessary to relocate to our ...
Cooling Towers: Open evaporative cooling towers use water to dissipate heat from a process, usually via a heat exchanger. Unfortunately damage to these systems can arise and therefore proper monitoring and maintenance is required to prevent damage ...

Service providerbased inToronto, ONTARIO (CANADA)
Strategies for the Environment Inc. offers consulting, training and auditing services in environmental, quality, health and safety management. Strategies for the Environment Inc. will help your company achieve its goals, whether its meeting your ...

Service providerbased inMumbai, INDIA
SIDDHARTH ENTERPRISES is recognized as an Organization specializing in the Business of Emergency Repair And Preventive Maintenance. We offer innovative and High Quality Solutions for Sealing of Leakage to the Oil Refineries, Oil Explorations (On ...
The tubular Absorbent socks are a very cost effective way of recovering small and medium sized oil spills from calm waters. They can be used around machines and equipment to prevent spilled oil from spreading. Available is short Lengths and smaller ...